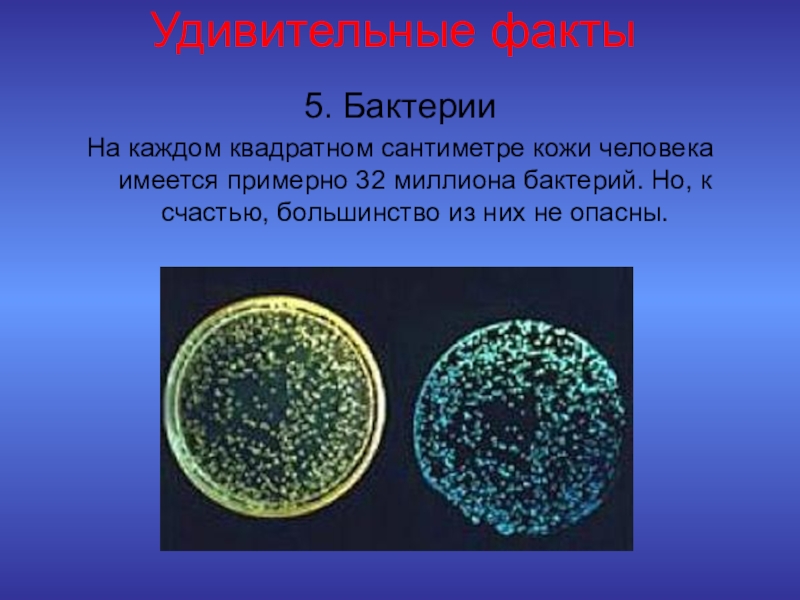

СОШ п. Кубово Шевченко З.Г.
- Главная
- Разное
- Образование
- Спорт
- Естествознание
- Природоведение
- Религиоведение
- Французский язык
- Черчение
- Английский язык
- Астрономия
- Алгебра
- Биология
- География
- Геометрия
- Детские презентации
- Информатика
- История
- Литература
- Математика
- Музыка
- МХК
- Немецкий язык
- ОБЖ
- Обществознание
- Окружающий мир
- Педагогика
- Русский язык
- Технология
- Физика
- Философия
- Химия
- Шаблоны, фоны, картинки для презентаций
- Экология
- Экономика
Презентация, доклад - игра по биологии Познай себя, человек! (Удивительный человек), 8 класс
Содержание
- 1. Презентация - игра по биологии Познай себя, человек! (Удивительный человек), 8 класс
- 2. «Удивительный» ЧЕЛОВЕКИнтересная информация о строении и функциях человека
- 3. «Удивительный» человекО строении тела человека и его
- 4. Знаете ли Вы?1.За сутки человек выделяет столько
- 5. Знаете ли Вы?8.Скелет взрослого человека состоит из
- 6. Удивительные фактыЧто же мы знаем о своем
- 7. Удивительные факты1.Рисунок языкаКаждый язык имеет свой отпечаток, как и пальцы на руках.
- 8. Удивительные факты
- 9. Удивительные факты3. Запоминание запаховНос человека не такой
- 10. 4. Длина кишечникаДлина тонкого кишечника примерно в
- 11. Удивительные факты5. БактерииНа каждом квадратном сантиметре кожи человека
- 12. Удивительные факты
- 13. Удивительные факты7. Потребность во снеЧеловек может обойтись без сна лишь 11 дней. После этого он умирает.
- 14. Удивительные факты8.Количество слюныЗа свою жизнь человеческий организм
- 15. Викторина «Наше тело» Вопросы викторины1. Чем покрыто
- 16. Викторина «Наше тело» Ответы викторины1. Кожа2. Сердце3.
- 17. Здоровье человекаНет ничего дороже в жизни человека, чем его здоровье.
- 18. Пословицы о здоровье 1. Береги
- 19. Пословицы о здоровье 1. Береги
- 20. Отгадай…1.Что у человека может осипнуть?2. Как называется
- 21. Проверь…1. Голос2. Насморк3. Эмаль4. Нерв5. Рёбра
- 22. И в шутку,
- 23. И в шутку, и
- 24. И в шутку, и
- 25. И в шутку,
- 26. Синквейн: человекСоставление синквейна заставляет анализировать и чётко
- 27. Синквейн: человек1. Человек2. Сложный и разумный3. Растёт,
- 28. Спасибо за внимание !Берегите своё здоровье и «прислушивайтесь» к своему телу.Соавтор: Шевченко Анастасия, 10 лет
«Удивительный» ЧЕЛОВЕКИнтересная информация о строении и функциях человека
Слайд 1Познай себя, человек!
Внеклассное мероприятие по биологии, 8 класс
Автор: учитель биологии МКОУ
Слайд 3«Удивительный» человек
О строении тела человека и его функциях известно, пожалуй, уже
всё…
Но мы не перестаём удивляться сложности и совершенству человеческого организма.
Но мы не перестаём удивляться сложности и совершенству человеческого организма.
Слайд 4Знаете ли Вы?
1.За сутки человек выделяет столько тепла, что его хватит,
чтобы довести до кипения 33 литра ледяной воды.
2.Человек более 20 лет из 60 проводит во сне, т.е. спит 1/3 жизни.
3. Вода составляет примерно 2/3 массы человека.
4. В организме человека примерно 150 миллиардов капилляров.
5. Масса сердца взрослого человека от 250 до 300 гр.
6. Вес головного мозга взрослого человека 1200-1300 гр.
7. В организме человека примерно 5 литров крови.
2.Человек более 20 лет из 60 проводит во сне, т.е. спит 1/3 жизни.
3. Вода составляет примерно 2/3 массы человека.
4. В организме человека примерно 150 миллиардов капилляров.
5. Масса сердца взрослого человека от 250 до 300 гр.
6. Вес головного мозга взрослого человека 1200-1300 гр.
7. В организме человека примерно 5 литров крови.
Слайд 5Знаете ли Вы?
8.Скелет взрослого человека
состоит из 206 костей.
9. В 1
мм3 крови содержится 5 млн. эритроцитов, 6 - 8 тыс. лейкоцитов, 200 – 300 тромбоцитов.
10. Пищеварительная трубка имеет длину 7 – 8 метров, а длина тонкого кишечника 3 – 3,5 метров.
11. В сутки у взрослого человека выделяется 1 литр слюны.
12. В сутки у взрослого человека образуется 1, 5 литра мочи.
10. Пищеварительная трубка имеет длину 7 – 8 метров, а длина тонкого кишечника 3 – 3,5 метров.
11. В сутки у взрослого человека выделяется 1 литр слюны.
12. В сутки у взрослого человека образуется 1, 5 литра мочи.
Слайд 6Удивительные факты
Что же мы знаем о своем собственном теле?
Мы радуемся,
едим, спим, гуляем, а наше тело живет само по себе, и все процессы в нем происходят сами по себе. И человек не может их контролировать и, порой, даже не подозревает, что в нём происходит.
Вот несколько удивительных фактов о
человеческом теле.
Вот несколько удивительных фактов о
человеческом теле.
Слайд 8Удивительные факты
2. Наши кости
У взрослого человека костей меньше, чем у ребенка. Ребенок рождается с 350 костями. Но в процессе роста они срастаются, и в конце концов, у взрослого человека остается только 206 костей.
У взрослого человека костей меньше, чем у ребенка. Ребенок рождается с 350 костями. Но в процессе роста они срастаются, и в конце концов, у взрослого человека остается только 206 костей.
Слайд 9Удивительные факты
3. Запоминание запахов
Нос человека не такой чувствительный, как у животных.
Но, не смотря на это, он может «запомнить» 50 000 различных ароматов.
Слайд 104. Длина кишечника
Длина тонкого кишечника примерно в 2 раза длиннее высоты
среднего взрослого человека. Это примерно 3 - 3,5 метров. И если он не был уложен в брюшной полости петлями, то …просто бы не вместился.
Удивительные факты
Слайд 11Удивительные факты
5. Бактерии
На каждом квадратном сантиметре кожи человека имеется примерно 32 миллиона
бактерий. Но, к счастью, большинство из них не опасны.
Слайд 12Удивительные факты
6. Кровь
В теле человека примерно 96 561 км кровеносных сосудов. Этот путь проходит кровь почти мгновенно. А трудолюбивое сердце каждый день перекачивает около 20 000 литров крови.
В теле человека примерно 96 561 км кровеносных сосудов. Этот путь проходит кровь почти мгновенно. А трудолюбивое сердце каждый день перекачивает около 20 000 литров крови.
Слайд 13Удивительные факты
7. Потребность во сне
Человек может обойтись без сна лишь 11
дней.
После этого он умирает.
После этого он умирает.
Слайд 14Удивительные факты
8.Количество слюны
За свою жизнь человеческий организм производит примерно 25 000
литров слюны. Этого количества хватило бы, чтобы заполнить 2 бассейна.
Слайд 15Викторина «Наше тело»
Вопросы викторины
1. Чем покрыто тело человека от макушки до
кончиков
пальцев?
2. Какой орган человека называют «мотором»?
3. Их у человека двадцать.
4. Орган зрения.
5. Главное отделение «внутренней кухни».
6. Соседка желудка с правой стороны.
7. Всегда во рту, а не проглотишь.
8. Орган, похожий на извилистый лабиринт.
9. Защищает и прикрывает глаз.
10. Что носит человек много лет, а счета им не знает?
11. Какой орган человека называют «командным пунктом»?
12. Что встречается в человеческом теле 32 раза?
13.Часть уха, на которой носят сережки.
пальцев?
2. Какой орган человека называют «мотором»?
3. Их у человека двадцать.
4. Орган зрения.
5. Главное отделение «внутренней кухни».
6. Соседка желудка с правой стороны.
7. Всегда во рту, а не проглотишь.
8. Орган, похожий на извилистый лабиринт.
9. Защищает и прикрывает глаз.
10. Что носит человек много лет, а счета им не знает?
11. Какой орган человека называют «командным пунктом»?
12. Что встречается в человеческом теле 32 раза?
13.Часть уха, на которой носят сережки.
Слайд 16Викторина «Наше тело»
Ответы викторины
1. Кожа
2. Сердце
3. Пальцы
4. Глаза
5. Желудок
6. Печень
7. Язык
8.
Кишечник
9. Веко
10. Волосы
11. Мозг
12. Зубы
13. Мочка
9. Веко
10. Волосы
11. Мозг
12. Зубы
13. Мочка
Слайд 18
Пословицы о здоровье
1. Береги платье снову, а здоровье …
2. Чистота –
половина…
3. Было бы здоровье, а счастье…
4. Двигайся больше – проживёшь…
5. Здоровье сгубишь – новое…
6.Смолоду закалиться – на век…
7. В здоровом теле…
3. Было бы здоровье, а счастье…
4. Двигайся больше – проживёшь…
5. Здоровье сгубишь – новое…
6.Смолоду закалиться – на век…
7. В здоровом теле…
Слайд 19
Пословицы о здоровье
1. Береги платье снову, а здоровье (смолоду.)
2. Чистота –
половина (здоровья.)
3. Было бы здоровье, а счастье (найдётся.)
4. Двигайся больше – проживёшь (дольше.)
5. Здоровье сгубишь – новое (не купишь.)
6.Смолоду закалиться – на век (пригодится.)
7. В здоровом теле – (здоровый дух.)
3. Было бы здоровье, а счастье (найдётся.)
4. Двигайся больше – проживёшь (дольше.)
5. Здоровье сгубишь – новое (не купишь.)
6.Смолоду закалиться – на век (пригодится.)
7. В здоровом теле – (здоровый дух.)
Слайд 20Отгадай…
1.Что у человека может осипнуть?
2. Как называется простуда носа?
3. Зубное
покрытие.
4. Что в зубе убивают мышьяком?
5. Что у человека 12 пар, а у монеты всего одно?
4. Что в зубе убивают мышьяком?
5. Что у человека 12 пар, а у монеты всего одно?
Слайд 22 И в шутку, и всерьёз…
1.Какая температура
тела обычно бывает у заболевшего гриппом человека?
а) Минусовая
б) Нормальная
в) Повышенная
г) Комнатная
2.Что из перечисленного НЕ является болезнью? а) Малокровие б) Белокровие в) Хладнокровие.
а) Минусовая
б) Нормальная
в) Повышенная
г) Комнатная
2.Что из перечисленного НЕ является болезнью? а) Малокровие б) Белокровие в) Хладнокровие.
Слайд 23 И в шутку, и всерьёз…
3. Как называются
микроорганизмы, провоцирующие возникновение инфекционных болезней?
а) Воздыхатели
б) Возбудители
в) Возмутители
г) Подстрекатели.
4. Как по - простому называется детская болезнь, при которой распухают околоушные железы? а) Хрюшка б) Свинка в) Кабанчик г) Поросёнок
г) Подстрекатели.
4. Как по - простому называется детская болезнь, при которой распухают околоушные железы? а) Хрюшка б) Свинка в) Кабанчик г) Поросёнок
Слайд 24 И в шутку, и всерьёз…
5. Что получает пациент на руки после рентгеновской съёмки?
а) Снимок
б) Видеоклип в) Кинофильм
г) Премию «Оскар»
6.Что нередко теряет человек при солнечном ударе? а) Терпение
б) Совесть в) Сознание
г) Чувство юмора.
б) Видеоклип в) Кинофильм
г) Премию «Оскар»
6.Что нередко теряет человек при солнечном ударе? а) Терпение
б) Совесть в) Сознание
г) Чувство юмора.
Слайд 25 И в шутку, и всерьёз…
7.
Какая кислота находится у нас в желудке?
а) Серная кислота
б) Лимонная кислота
в) Соляная кислота
г) Уксусная кислота
8.Что происходит с желудком после поглощения
неудобоваримой пищи? а) Он расстраивается б) Он огорчается в) Он обижается г) Он оскорбляется.
8.Что происходит с желудком после поглощения
неудобоваримой пищи? а) Он расстраивается б) Он огорчается в) Он обижается г) Он оскорбляется.
Слайд 26Синквейн: человек
Составление синквейна заставляет анализировать и чётко формулировать свои мысли, использовать
ёмкие понятия, учит обобщать и выделять главное.
Правила составления синквейнов:
Синквейн – творческое упражнение, заставляющее размышлять на заданную тему.
Cing – по –французски значит «пять».
Классический синквейн – это пятистрочная строфа, составленная по определённым правилам.
1. Первая строка содержит одно слово – термин, понятие, фамилию.
2.Вторая строка содержит два слова (существительные или прилагательные) - определение предмета, личности.
3. Третья строка содержит три глагола, характеризующих деятельность объекта.
4. Четвёртая строка содержит краткое предложение (из 4-5 слов), раскрывающих смысл главного слова синквейна.
5. Пятая строка – одно слово, являющееся синонимом по отношению к объекту синквейна или определяющее эмоцию автора по отношению к этому слову.
Правила составления синквейнов:
Синквейн – творческое упражнение, заставляющее размышлять на заданную тему.
Cing – по –французски значит «пять».
Классический синквейн – это пятистрочная строфа, составленная по определённым правилам.
1. Первая строка содержит одно слово – термин, понятие, фамилию.
2.Вторая строка содержит два слова (существительные или прилагательные) - определение предмета, личности.
3. Третья строка содержит три глагола, характеризующих деятельность объекта.
4. Четвёртая строка содержит краткое предложение (из 4-5 слов), раскрывающих смысл главного слова синквейна.
5. Пятая строка – одно слово, являющееся синонимом по отношению к объекту синквейна или определяющее эмоцию автора по отношению к этому слову.
Слайд 27Синквейн: человек
1. Человек
2. Сложный и разумный
3. Растёт, развивается и думает
4. Сложная
биоэнергетическая система
5. Вид: Homo sapiens – человек разумный
5. Вид: Homo sapiens – человек разумный
Слайд 28Спасибо за внимание !
Берегите своё здоровье и «прислушивайтесь» к своему телу.
Соавтор:
Шевченко Анастасия, 10 лет